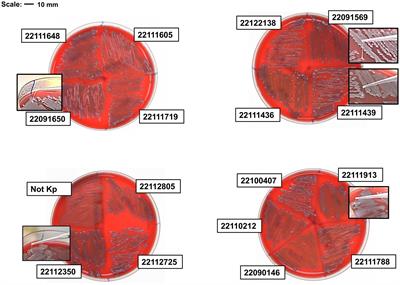

Methods
Published on 05 Oct 2023
Maternal supplementation with Limosilactobacillus reuteri FN041 for preventing infants with atopic dermatitis: study protocol for a randomized controlled trial
in Microorganisms in Vertebrate Digestive Systems
- 3,707 views
- 3 citations